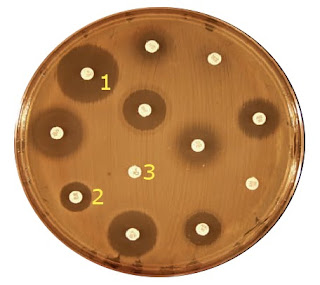

Desde a descoberta da penicilina, muitos outros antibióticos foram
descobertos e outros sintetizados em laboratórios, mas há a necessidade
de fazer o Teste de Sensibilidade aos Antibióticos (TSA) (Figura 1) para que possa avaliar qual deles terá resultados satisfatórios para agir de forma bactericida ou bacteriostática e escolher o melhor tratamento ao paciente.
|
| Figura 1: Teste de Sensibilidade aos Antibióticos (TSA). |
O TSA é realizado da seguinte maneira:
- Colhe o material com os microorganismos do paciente (saliva, fluido, mucosa, etc);
- Semeia o material coletado numa gelativa nutritiva contida na placa de Pétri;
- Adiciona esferas de papel com antibióticos diferenciados;
- Tampa a placa de Pétri e leva à estufa para dar um ambiente favorável ao crescimento dos microorganismos;
- Depois de alguns dias, retira-se a placa de Pétri e verifica-se os resultados.
Em algumas esferas tem uma grande formação de halos, mostrando que os antibióticos tiveram forte ação sobre os microorganismos semeados na placa que se distanciaram (1), já nos outros formou-se pouco ou nenhum halo ao redor das esferas mostrando pouca (2) ou nenhuma ação aos microorganismos (3).
Abraços!

Nenhum comentário:
Postar um comentário